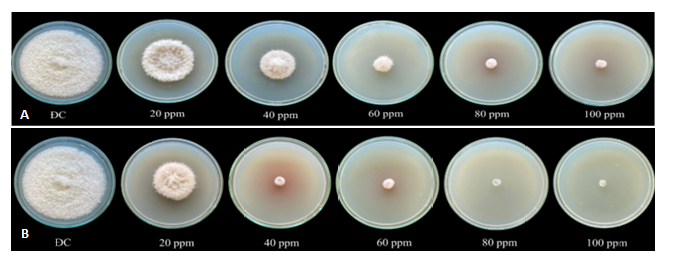

Hoạt tính kháng nấm bệnh thực vật fusarium oxysporum của nano đồng
Bài báo Hoạt tính kháng nấm bệnh thực vật fusarium oxysporum của nano đồng do TS. Trương Thị Hạnh (Viện Tiên tiến Khoa học và Công nghệ, Trường Đại học Văn Lang) thực hiện.
TÓM TẮT:
Trong nghiên cứu này, nano đồng được tổng hợp bằng phương pháp khử hóa học Cu2+ với chất khử NaHB4 trong chất ổn định chitosan. Đặc tính của hạt nano đồng được xác định bằng phổ UV-Vis, nhiễu xạ tia X (XRD) và kính hiển vi điện tử truyền qua (TEM). Hiệu quả kháng nấm của CuNP được đánh giá bằng thử nghiệm chống nấm Fusarium oxysporum ở các nồng độ khác nhau từ 20 - 100 ppm. Kết quả cho thấy các mẫu hạt nano đồng đã ức chế đáng kể sự phát triển của Fusarium oxysporum và đường kính hạt càng nhỏ thì hiệu quả kháng nấm càng cao. Các hạt nano đồng có kích thước 26,5 nm cho thấy hiệu quả kháng nấm cao hơn các hạt nano đồng 29 nm. Sự ức chế hoàn toàn được quan sát thấy ở nồng độ ³80 ppm sau 1 ngày và thậm chí 7 ngày nuôi cấy đối với mẫu 2.0 CuNP (26.5 nm), trong khi nấm vẫn tồn tại trên các đĩa PDA chứa 1.5 CuNP (29 nm).
Từ khóa: hoạt tính kháng nấm, bệnh thực vật, fusarium oxysporum, nano đồng.
1. Đặt vấn đề
Trong nhiều thập kỷ, ion Cu2+ đã được sử dụng làm thuốc diệt nấm trong nông nghiệp. Tuy nhiên, sự tích tụ ion Cu2+ trong hệ sinh thái đất sẽ gây bất lợi cho môi trường. Vì vậy, việc thay thế các hạt nano đồng cho ion Cu2+ là cần thiết để phát triển các loại thuốc diệt nấm hiệu quả lâu dài, thân thiện với môi trường và tiết kiệm chi phí.
2. Tổng quan nghiên cứu
Đồng là một vi chất dinh dưỡng thiết yếu để duy trì sức khỏe và dinh dưỡng hiệu quả cho cây trồng. Nó đóng một vai trò quan trọng trong quá trình tổng hợp chất diệp lục, sắc tố thực vật và chuyển hóa protein, cũng như carbohydrat (Rai et al, 2018). Thiếu Cu có thể dẫn đến nhiều bệnh khác nhau ở cây trồng dẫn đến giảm năng suất. Sự thiếu hụt Cu cũng ảnh hưởng đến sự phát triển sinh dưỡng, hình thành hạt, quả và giảm sự phân chia tế bào. Hơn nữa, Cu và các hợp chất của nó có hoạt tính diệt khuẩn và diệt nấm vượt trội, do đó chúng được sử dụng để kiểm soát các bệnh trên cây trồng. Dung dịch Boóc-đô (Bordeaux) đã được biết đến trên toàn cầu, vì nó là một loại thuốc diệt nấm hiệu quả bao gồm đồng sunfat và nước vôi. Hỗn hợp này được các nhà khoa học Pháp phát minh và phát triển thành chất bảo vệ thực vật chống lại bệnh sương mai lây nhiễm trên cây nho (Gadi and Jeffrey G., 2009). Đồng sunfat là thành phần chính trong hầu hết các loại thuốc diệt nấm có bán trên thị trường cho trang trại và vườn tược. Hiện nay, canh tác hữu cơ đang được áp dụng nhằm tìm kiếm chất thay thế đồng trong bảo vệ cây trồng và giảm thiểu lượng Cu bón vào. Tuy nhiên, không có hoạt chất, kỹ thuật hoặc phương pháp nào có thể thay thế hoàn toàn cho Cu (Stefan và cộng sự, 2018).
Việc sử dụng hóa chất nông nghiệp để chống lại bệnh cây trồng có lợi ích kinh tế trực tiếp giảm mất mùa. Tuy nhiên, việc sử dụng thường xuyên thuốc trừ sâu với số lượng lớn đã gây ra tác hại to lớn cho con người và môi trường do tích tụ dư lượng trong sản phẩm và đất (Elizabeth và cộng sự, 2018). Hơn nữa, việc sử dụng tác nhân này đã dẫn đến khả năng kháng thuốc của các vi sinh vật (Aflag và cộng sự, 2022). Như vậy, việc ứng dụng công nghệ nano trong nông nghiệp ngày càng được quan tâm bởi ứng dụng bảo vệ thực vật, thúc đẩy tăng trưởng thực vật, hoạt động kháng nấm và kháng khuẩn. Đặc biệt, hạt nano đồng gần đây được quan tâm nhiều hơn, vì tính hiệu quả về mặt chi phí, hạt nano đồng (CuNP) rẻ hơn nhiều so với hạt nano bạc hoặc vàng. Xử lý CuNP cho cây trồng cho thấy hiệu quả thúc đẩy tăng trưởng về chiều cao cây, chiều dài rễ, trọng lượng rễ, số nốt sần, trọng lượng nốt sần và số lượng quả trên mỗi cây trong cả thí nghiệm trồng trong chậu và đồng ruộng (Chunwei và cộng sự, 2006)
Gần đây, qua các khảo sát cho thấy việc kết hợp CuNP vào các polyme tự nhiên, cụ thể như xenlulo, tinh bột và chitosan đã tăng cường đáng kể hoạt tính kháng khuẩn và kháng nấm của nó (Arjunan và cộng sự, 2017, Margarita và cộng sự, 2017). CuNPs-Chitosan có thể kết hợp các đặc tính của polyme sinh học và đồng nano, làm tăng cường hiệu ứng cộng hợp của các thành phần, do đó, việc ứng dụng chúng có thể hiệu quả hơn so với việc sử dụng riêng lẻ.
Trong nghiên cứu này, CuNP được tổng hợp bằng phương pháp khử hóa học. Dung dịch keo CuNP được tạo thành từ dung dịch ion Cu2+ 20 mM bằng cách khử natri borohydrua (NaBH4) ở 80oC. Chitosan được sử dụng làm tác nhân ổn định cho hạt nano đồng. Các đặc tính hóa lý và hoạt tính kháng nấm của CuNPs-chitosan chống lại Fusarium oxysporum đã được nghiên cứu.
3. Vật liệu và phương pháp
Tất cả các hóa chất đều thuộc loại phân tích. Muối pentahydrat đồng (II) sunfat CuSO4,5H2O có độ tinh khiết 98,0% (Merck). Sodium borohydride (NaBH4, Reagent Plus 99,0%) từ Sigma-Aldrich được sử dụng làm chất khử chính, trong khi axit ascorbic (99,7%, Prolabo) được sử dụng làm chất chống oxy hóa cho keo nano đồng. Chất ổn định chitosan có độ deacetyl khoảng 80% và Mw = 1,06 × 105. Nước cất được sử dụng cho pha chế dung dịch.
3.1. Chế tạo nano đồng
Hòa tan 10 mL CuSO4.5H2O (0,1 M) trong 90 mL dung dịch chitosan ở nồng độ 1.5 và 2.0 % (w/v, g/mL) bằng dung môi axit lactic. Sau đó, thêm 0,5 mL axit ascorbic - C6H8O6 (0,01M) khuấy mạnh ở 80oC trong 15 phút. Tiếp theo, nhỏ từ từ 0,5 mL thể tích chất khử NaBH4 (4 mM) vào hỗn hợp trên cho đến khi màu chuyển từ hơi xanh sang tía đậm chứng tỏ đã hình thành CuNP. Khuấy liên tục trong 20 phút cho đến khi phản ứng xảy ra hoàn toàn. Mẫu nano đồng với 1.5% và 2.0% chitosan được ký hiệu lần lượt là 1.5 CuNP và 2.0 CuNP.
3.2. Đặc trưng của nano đồng
Phổ UV-vis của keo CuNP được ghi trên máy quang phổ Jasco V- 630 bước sóng từ 200-600 nm, ảnh TEM của CuNP được chụp trên kính hiển vi điện tử JEOL, JEM-2100, gia tốc 120 kV. CuNP rắn được tách khỏi chất keo bằng cách ly tâm siêu tốc 40.000 vòng/phút, sau đó sấy khô ở 80oC. Mẫu nhiễu xạ tia X (XRD) của CuNP tinh thể được đo trên thiết bị Shimadzu 5A với bức xạ CuKα (25 kV và 25 mA), quét ở tốc độ 0,5◦/phút từ 5 đến 80◦ (2θ). Hạt nano đồng tinh thể đã được ước tính bằng cách sử dụng công thức Debey-Scherrer:
D =kλ/(β cosθ) (1)
Trong đó, k = 0,89, λ là bước sóng của tia X (1,5405 Å), ß là độ bán rộng cực đại (FWHM), θ là góc nhiễu xạ (Bragg) và D là kích thước đường kính hạt (Muhammad và cộng sự, 2012).
3.3. Thí nghiệm hoạt tính kháng nấm
Các mẫu nấm Fusarium oxysporum (F. oxysporum) được phân lập từ cà chua bị nhiễm bệnh, sau đó được nuôi trên môi trường thạch D-glucose khoai tây (PDA). Môi trường này bao gồm 1000 mL nước cất, 200 g/L chiết xuất khoai tây, 20 g/L agar và 20 g/L glucose. CuNP keo ở nồng độ 0, 20, 40, 60, 80 và 100 ppm được đưa vào môi trường PDA, hấp ở 121oC trong 15 phút. Tiếp theo, lắc hỗn hợp rồi đổ vào đĩa petri đã khử trùng (90×15 mm). Môi trường chứa CuNP được ủ ở nhiệt độ phòng trong 48 giờ. Sau đó, mỗi đĩa Petri được cấy vào trung tâm một đĩa sợi nấm (đường kính 6 mm) lấy ở khuẩn lạc F. oxysporum, được trồng trên PDA. Sau khi ủ ở 28oC trong 1, 2, 3, 4, 5, 6 và 7 ngày, ghi nhận sự phát triển của sợi nấm. Sự ức chế được xác định khi sự phát triển của sợi nấm trong đĩa đối chứng đạt đến mép đĩa petri. Công thức để tính hiệu ứng ức chế tăng trưởng (%) được Margarita mô tả như sau:

Trong đó, d0 là đường kính phát triển nấm trong các đĩa đối chứng và da lần lượt là đường kính phát triển nấm trong các đĩa có CuNP (Margarita và cộng sự, 2017).
Tất cả các thử nghiệm về sự phát triển của nấm được thực hiện 3 lần và dữ liệu được trình bày dưới dạng độ lệch chuẩn trung bình.
4. Kết quả và thảo luận
4.1. Chế tạo nano đồng bằng phương pháp khử hóa học
Trong nghiên cứu này, CuNP được điều chế bằng cách khử muối đồng - CuSO4 bằng tác nhân NaBH4 trong chất ổn định chitosan ở 80oC và chất chống oxy hóa axit ascorbic. Cơ chế khử ion Cu2+ thành nguyên tử Cu0 và keo tụ tạo nano đồng có thể được đề nghị như sau:
Cu2+ + 2BH4─ → Cu0 + B2H6 + H2 (3)
nCu0 → Cun (4)
nCu2+R → nCu0R → CunRn (R chitosan) (5)
Sự hình thành keo CuNP có thể được quan sát bằng mắt, bởi sự thay đổi màu của hỗn hợp từ xanh lam sang đỏ tía. Sự liên kết của Cu và chitosan đạt được thông qua sự tạo phức của cả hai nhóm amin và hydroxyl với ion Cu2+, sau đó là nguyên tử Cu. Ngoài ra, các nhóm amin khác của chitosan trong môi trường axit được proton hóa để tạo thành các ion -NH3+, do đó các hạt nano kim loại như CuNP có thể được ổn định bởi chitosan thông qua lực đẩy tĩnh điện, cũng như lực cản không gian chelate (Hạnh cộng sự, 2017). Việc sử dụng polyme sinh học làm chất ổn định và chất khử là một giải pháp thân thiện với môi trường thay thế cho các dung môi hữu cơ độc hại (Appu và cộng sự, 2015).
Trong quá trình khử Cu2+ thành Cu0 và keo tụ thành CuNP, quá trình oxy hóa thành Cu2O hoặc CuO dễ dàng xảy ra, do đó axit ascorbic được thêm vào hỗn hợp ban đầu để tăng cường khả năng khử và chống oxy hóa, nhằm loại bỏ các gốc tự do và các phân tử oxy phản ứng (Hạnh cộng sự, 2022).
Phân tích quang phổ hấp thụ UV-vis để xác nhận keo nano đồng (Hình 1). Đỉnh hấp thụ của nano Cu có bước sóng trong vùng 500-600 nm (Alejandro cộng sự, 2020). Ảnh hưởng của nồng độ chitosan được chứng tỏ qua sự dịch chuyển đỉnh hấp thụ λ = 575,5 nm đến λ =574 nm tương ứng đối với CuNP dạng keo trong 1.5% và 2.0% chitosan. Điều này có nghĩa kích thước của CuNP giảm và độ phân tán CuNP tốt hơn khi tăng nồng độ chất ổn định. Nồng độ chitosan được duy trì ở dung dịch 1.5 và 2%, vì điều này cung cấp đủ chitosan để ổn định CuNP và cũng cho phép độ nhớt của dung dịch chấp nhận được ở nhiệt độ phòng.

4.2. Đặc trưng của hạt nano đồng
Hình 2 cho thấy các đỉnh nhiễu xạ của CuNP từ 20-80◦, các đỉnh xuất hiện ~ 25o có thể do cấu trúc của chitosan (Muhammad cộng sự, 2013). Các góc Bragg 2θ = 43,3◦, 52,1◦ và 74,2◦ lần lượt là các mặt phẳng (111), (200) và (220) của tinh thể đồng. Kết quả này phù hợp với các vị trí đỉnh XDR của Cu đã được công bố trước đây (Vippola cộng sự, 2016). Độ bán rộng cực đại (FWHM) của đỉnh nhiễu xạ (111) ~ 43◦ trong Hình 2b được sử dụng để xác định kích thước tinh thể trung bình theo công thức Debye-Scherrer (1). Kích thước tinh thể của CuNP được xác đinh 29 nm và 26,5 nm ứng với các mẫu 1.5 CuNP (Hình 2 (b1)) và 2.0 CuNP (Hình 2 (b2)). Khi các nhân được hình thành, chúng có xu hướng tập hợp lại để làm giảm tổng năng lượng bề mặt. Việc sử dụng chitosan làm chất ổn dịnh kích thước hạt nano trong nghiên cứu này giúp tránh sự kết tụ của các hạt nano bằng hiệu ứng không gian. Như vậy, kích thước CuNP nhỏ hơn khi nồng độ chitosan cao hơn ở cùng điều kiện phản ứng. Ảnh TEM cung cấp thông tin về hình thái của hạt nano (Vippola cộng sự, 2016). Hình 3 cho thấy CuNP có dạng hình cầu và sự phân bố hạt tương đối đồng nhất và không có sự kết tụ.

Thử nghiệm kháng nấm được thực hiện với các mẫu gồm 1.5 CuNP (Hình 4, dãy A) và 2.0 CuNP (Hình 4, dãy B) tương ứng với đường kính của CuNP khoảng 29 nm và 26,5 nm. Hoạt tính kháng nấm của CuNP tổng hợp được đánh giá bằng cách đo đường kính nấm của các đĩa thực nghiệm. Hình 4 thể hiện sự ức chế tăng trưởng của nấm F. oxysporum trên các đĩa nuôi cấy CuNP ở các nồng độ khác nhau là 20, 40, 60, 80 và 100 ppm, sau thời gian ủ 7 ngày.

Trong hầu hết các trường hợp, đường kính nấm ở các mẫu được bổ sung CuNP đều nhỏ hơn so với các mẫu đối chứng không có CuNP (ĐC), đặc biệt thể hiện rõ ở nồng độ ³ 40 ppm đối với 2.0 CuNPs (dãy B) và ³ 60 ppm đối với 1.5 CuNP (dãy A).
Trong nghiên cứu này, hiệu quả kháng nấm có thể được giải thích bằng cơ chế “diệt tiếp xúc” của hạt nano đồng đã được nhiều tác giả công bố (Gregor cộng sự, 2011; Ma cộng sự 2022) . Không có vi sinh vật sống sót từ bề mặt đồng sau khi tiếp xúc kéo dài bởi sự tổn thương màng tế bào, từ sự trương lớn và biến mất của không bào. Sự kết hợp giữa CuNP và chitosan mang lại tác dụng “cộng hợp” lên hoạt tính kháng nấm của các thành phần. Hoạt động trực tiếp của chitosan chống lại virus, vi khuẩn và nấm đã được cho là ngừng hoạt động sao chép và lan rộng (Xing cộng sự, 2015). Hoạt tính kháng nấm mẫu 2.0 CuNP hiệu quả hơn 1.5 CuNPs bởi 2 yếu tố, đó là kích thước hạt nhỏ hơn và nồng độ chitosan cao hơn.
5. Kết luận
Hạt nano đồng/chitosan được tổng hợp bằng phương pháp khử hóa học bằng NaHB4 với Cu2+ ion. Các kỹ thuật phân tích như phổ UV Vis và ảnh TEM đã xác nhận sự hình thành các hạt nano đồng trong chitosan. Kết quả thử nghiệm in vitro cho thấy CuNP ức chế đáng kể sự phát triển của mầm bệnh F. oxysporum đối với cây trồng nhiệt đới theo kích thước của CuNP. Các thí nghiệm ban đầu đã chứng minh CuNP có triển vọng sử dụng làm thuốc diệt nấm theo cách chế tạo đơn giản và tiết kiệm chi phí. Tất nhiên, các thử nghiệm in vivo sâu hơn về hiệu quả kháng nấm, cũng như tác động của CuNP đến môi trường và các sinh vật có lợi khác sẽ được nghiên cứu trong tương lai.
TÀI LIỆU THAM KHẢO:
- Aflaq H., Sahar S. (2022). Role of nanoparticles in management of plant pathogens and scope in plant transgenics for imparting disease resistance, Plant Prot. Sci., 58, 173-184.
- Alejandro P. L., Javier P., Alma V. D., et al. 2020. Comparison of the In Vitro Antifungal and Anti-fumonigenic Activitie sof Copper and Silver Nanoparticles Against Fusarium verticillioides, J. Clust. Sci., 31, 213-220.
- Appu M, Muthukrishnan S. (2015). Green synthesis of copper-chitosan nanoparticles and study of its antibacterial activity. J. Nanomed. Nanotechnol. 6 1000251.
- Arjunan N., Singaravelu C.M., Kulanthaivael J., et al. (2017). A potential photocatalytic antimocribial and anticancer activity of chitosan-copper nanocomposite. Int. J. Biol. Macromol., 104, 1774-1782.
- Chunwei W., Brian P.M., Taofang Z. (2006). One-step green route to narrowly dispersed copper nanocrystals, J. Nanopart. Res., 8, 965-969.
- Elizabeth A.W., Aflaq H., Karishma T.M., et al., (2018). Review nanotechnology for plant disease management, Agronomy, 8, 285.
- Gadi B., Jeffrey G., 2009. Copper, an ancient remedy returning to fight microbial, fungal and viral infections, Curr. Chem. Biol., 3, 272-278.
- Gregor G, Christopher R and Marc S 2011. Minireviews metallic copper as an antimicrobial surface, Appl. Environ. Microbiol, 77, 1541-1547.
- Hanh T. T., Lan Chi N. T., Duy N. N. (2022). Fabrication of copper nanoparticles/diatomite nanocomposite by irradiation method for antibacterial application. Aquac. Rep. 27, 101342.
- Hanh T. T., Thu N. T., Quoc L. A., et al., (2017). Synthesis and characterization of silver/diatomite nanocomposite by electron beam irradiation Radiat. Phys. Chem. 139 141-147.
- Ma X., Zhou S., Xu X., et al. 2022. Copper-containing nanoparticles: Mechanism of antimicrobial effect and application in dentistry-a narrative review, Front Surg., 9, 905892.
- Margarita S.R., Alexander Y.V., Alexander V.N., et al. (2017). Synthesis and characterization of chitosan–copper nanocomposites and their fungicidal activity against two sclerotia–forming plant pathogenic fungi, J. Nanostruct. Chem., 7, 249 -258.
- Muhammad S.U., Nor A.I., Kamyar S., et al. (2012). Copper Nanoparticles Mediated by Chitosan: Synthesis and Characterization via Chemical Methods. Molecules, 17, 14928-14936.
- Muhammad S.U., Mohamed E. El. Z., Kamyar S., et al. (2013). Synthesis, characterization, and antimicrobial properties of copper nanoparticles, Int. J. Nanomed., 8, 4467-4479.
- Rai M., Ingle A.P., Pandit R., et al. (2018). Copper and copper nanoparticles: Role in management of insect-pests and pathogenic microbes, Nanotechnology Rev. 7, 303-315.
- Stefan K., Dietmar R., Peter R., et al. (2017). Organic farming the use of copper pesticides in Germany and the search for minimization and replacement strategies, Org. Farming, 3, 66-75.
- Vippola M., Valkonen M., Sarlin E., et al. 2016. Insight to nanoparticle size analysis-novel and convenient image analysis method versus conventional techniques, Nanoscale Res. Lett., 11, 169.
- Xing K., Zhu X., Peng X., et al. 2015. Chitosan antimicrobial and eliciting properties for pest control in agriculture: A review, Agron. Sustain. Dev., 35, 569-588.
Antiifungal Activity of Copper Nanopaticles Against Plant Pathogen Fusarium Oxysporum
PhD. TRUONG THI HANH
Science and Technology Advanced Institute, Van Lang University, Ho chi minh City, Vietnam
ABSTRAT:
In this study, copper nanoparticles (CuNP) were synthesized by chemical reduction of Cu2+ with reducing agent NaBH4 in a chitosan stabilizer. Characterization of CuNPs was performed using UV-Vis spectra, X-ray Diffraction (XRD) patterns and Transmission Electron Microscopy (TEM) images. The ability of CuNP to inhibit the growth of Fusarium oxysporum was investigated at concentrations between 20 and 100 ppm. The results showed that CuNP samples significantly inhibited the growth of Fusarium oxysporum, with smaller particle diameter exhibiting a higher antifungal effect. The 26.5 nm CuNPs displayed greater antifungal efficiency than the 29 nm CuNPs. Complete inhibition was observed at a concentration of ≥ 80 ppm after 7 days of culture for the 2.0 CuNP (26.5 nm) sample, while the fungus remained viable on PDA plates containing 1.5 CuNPs (29 nm).
Keywords: antifungal activity, plant pathogen, Fusarium oxysporum, copper nanoparticles.
[Tạp chí Công Thương - Các kết quả nghiên cứu khoa học và ứng dụng công nghệ, Số 15 tháng 6 năm 2024]